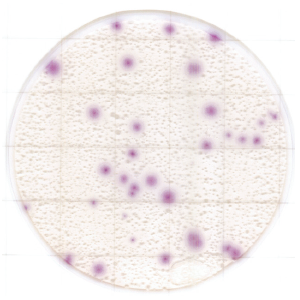
0616833428648486.png

相关产品推荐更多 >
万千商家帮你免费找货
0 人在求购买到急需产品
- 详细信息
- 文献和实验
- 技术资料
Easy Plate™ YM-R
酵母·霉菌检测用测试片

酵母·霉菌测试片,菌落呈紫色,即使存在食物残渣也能轻松识别和计数。
◆特点
● 菌落48小时即可清晰显色
● *若显色不清晰,可延长培养24小时
● (1)与琼脂培养基相比培养时间更短。
● (2)菌落呈紫色,即使存在食物残渣,也能轻松识别和计数。

检测样品:萨拉米香肠
*数据由NPO法人カビ相談センター提供
● 高性能培养
● 对多种食品测定,发现与标准琼脂培养基对比一致性高。

*数据由NPO法人カビ相談センター提供
◆判读及示例
■ 判读
菌落呈紫色,若要区分霉菌和酵母,请参考以下说明。
霉菌: 大型菌落,有扩散的边缘
酵母: 小型的圆形菌落,有明显的边缘

■ 显色示例
(1)菌株
| Aureobasidium pullulans |
Zygosaccharomyces rouxii |
|
|
|
| Geotrichum Candidum |
Aspergillus flavus |
|
|
|
(2)食品
| Dressing +Wickerhamomyces anomalus |
Mixed Powder |
|
|
|
| Egg Powder +Aspergillus niger |
Sweet |
|
|
|
※ 数据由NPO法人カビ相談センター提供
◆产品信息
| 产品编号 |
61977 |
| 产品名称 |
Easy Plate™ YM-R 酵母・霉菌快速检测用 |
| 微生物检测对象 |
酵母・霉菌 |
| 培养时间 |
48±2小时 |
| 培养温度 |
25±1℃ |
| 保存条件(未开封) |
2-8℃ |
| 有效期 |
生产日起 18 个月 |
点击此处下载产品宣传页
点击此处下载产品目录
风险提示:丁香通仅作为第三方平台,为商家信息发布提供平台空间。用户咨询产品时请注意保护个人信息及财产安全,合理判断,谨慎选购商品,商家和用户对交易行为负责。对于医疗器械类产品,请先查证核实企业经营资质和医疗器械产品注册证情况。
文献和实验Subcloning should be easy and fast, and work every time. The following protocols minimize
Subcloning should be easy and fast, and work every time. The following protocols minimize the number of manipulations required to prepare DNA fragments for ligations, thereby both saving time and increasing reliability. Preparation of DNA fragments
This Protocol allows for TRAFO with any Yeast cell source Referenece; Gietz, R.D. and R.A. Woods. (2002) TRANSFORMATION OF YEAST BY THE Liac/SS CARRIER DNA/PEG METHOD. Methods in Enzymology 350: 87-96.
技术资料暂无技术资料 索取技术资料